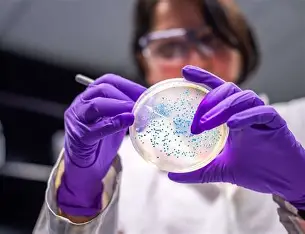

أفادت الدكتورة زاريما تين، أخصائية أمراض الباطنية، أن التخزين السليم للبيض واللحوم يقي من السالمونيلا، مشددة على أهمية استخدام ألواح تقطيع منفصلة وغسل اليدين لتقليل خطر العدوى.

وقالت الدكتورة تين إن البيض والدواجن يشكلان المصدر الرئيسي للعدوى، وأنه يمكن الوقاية من نحو 90% من الحالات باتباع الإجراءات الصحيحة، والتي تشمل:
-
شراء البيض واللحوم من المتاجر الموثوقة وتخزينهما في الثلاجة.
-
غسل البيض جيدا بالماء والصابون قبل الاستخدام.
-
تجنب تناول البيض النيء أو غير المسلوق جيدا، مثل البيض المسلوق نصف سلقة أو المقلي ذو الصفار السائل.
-
تقطيع لحوم الدواجن (الدجاج أو البط) على لوح تقطيع منفصل، وغسل اليدين والأدوات جيدا بالصابون بعد التعامل معها.
-
تخزين اللحوم والبيض في الثلاجة أسفل الأطعمة الجاهزة للأكل، مثل الجبن والسلطات والنقانق، لتجنب تلوثها بالسوائل.
وأوضحت الطبيبة أن الطهي الجيد أساسي للوقاية، إذ يجب سلق البيض لمدة لا تقل عن 10–12 دقيقة بعد بدء الغليان، وطهي اللحوم والدواجن حتى تنضج تماما، بحيث تصل درجة الحرارة الداخلية إلى 75 درجة مئوية على الأقل. كما شددت على غسل اليدين بالماء والصابون بعد استخدام المرحاض، وقبل تناول الطعام، وبعد ملامسة الحيوانات.
